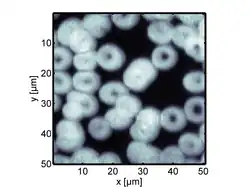

Erythrozyt

Die Erythrozyten oder Erythrocyten (Singular der Erythrozyt; von altgriechisch ἐρυθρός erythrós „rot“ sowie altgriechisch κύτος kýtos „Höhlung“, „Gefäß“, „Hülle“,[1] hier „Zelle“), oder rote Blutzellen, umgangssprachlich auch noch rote Blutkörperchen[2] genannt, sind die häufigsten Zellen im Blut von Wirbeltieren. Als einzige bekannte Ausnahme unter den Wirbeltieren besitzen die im Südpolarmeer vorkommenden Krokodileisfische keine Erythrozyten.[3] Sie dienen unter anderem dem Transport von Sauerstoff von der Lunge oder den Kiemen zu den diversen Körpergeweben. Die roten Blutzellen wurden erstmals 1658 von Jan Swammerdam als flachovale Teilchen im Froschblut und genauer 1673 von Antoni van Leeuwenhoek beschrieben.[4]
Reife Erythrozyten von Säugetieren erscheinen unter dem Mikroskop als ungefähr gleich große, blasse, runde Scheiben, die in der Mitte von beiden Seiten leicht eingedellt (bikonkav) sind und keinen Zellkern haben. Auch andere Organellen wie Mitochondrien und Ribosomen fehlen. Die Erythrozyten anderer Wirbeltiergruppen haben in der Regel Zellkerne, sie fehlen sonst nur bei einigen Fisch- und Amphibienarten. Bei einigen Arten sind die Erythrozyten etwa 200-mal so groß wie bei Arten mit den kleinsten.[5]
Zellen, die Sauerstoff transportierende Proteine enthalten, gibt es auch bei Tieren, die nicht zu den Wirbeltieren zählen: beispielsweise bei einigen Stachelhäutern, Weichtieren und Vielborstern.[5] Dort sind solche Zellen allerdings im Coelom außerhalb von Kreislaufsystemen zu finden. Lediglich bei Hufeisenwürmern gibt es ähnliche Zellen innerhalb des Blutkreislaufes.[5]
Zahlen zu den Erythrozyten des Menschen
- Durchmesser: im Mittel 7,5 μm
- Dicke: 2 μm am Rand und 1 μm im Zentrum
- Volumen: etwa 90 fl (Femtoliter)
- Durchschnittliche Konzentration im Blut: bei Männern 4,6–5,9·106/μl, bei Frauen 4,0–5,2·106/μl. (106/μl entsprechen 1012/l und 1/pl. In der klinischen Praxis werden 1012/l auch als Tera/l abgekürzt.)[6]
- Gesamtanzahl im Blut: 24–30 Billionen (24–30·1012)
- Entwicklungszeit: etwa 7 Tage
- Durchschnittliche Lebensdauer: etwa 120 Tage (4 Monate)
- Neuproduktion der Erythrozyten: etwa 1 %/Tag = etwa 200 Milliarden/Tag = etwa 2 Millionen/Sekunde
- Gesamtoberfläche aller Erythrozyten: 4000–4500 m²
- Osmotische Resistenz: bis 180 mosmol/l
- Membranpotential: −10 mV
Aufbau und Merkmale

Membran und Normalform
Auf der Zelloberfläche befinden sich verschiedene Glykoproteine (z. B. die Blutgruppen-Antigene), die u. a. die serologisch nachweisbaren genetischen Merkmale der Erythrozyten definieren.
Die Scheibenform verdanken Erythrozyten ihrem Membranskelett. Dieses besteht aus einem flächigen Netz aus Spektrin-Filamenten, die durch kurze Aktin-Filamente zusammen gehalten werden. Durch Vermittlung von Adapterproteinen, wie Ankyrin, ist das Netz an integralen Proteinen der Plasmamembran verankert. Zu den integralen Proteinen der Plasmamembran zählen der Anionen-Austauscher 1 und das Glykophorin.
Die bikonkave Form ermöglicht es den Erythrozyten, Sauerstoff schneller aufzunehmen, da die Diffusionsstrecke von der Zellmembran in das Innere der Zelle verkürzt ist und das Verhältnis von Oberfläche zu Volumen möglichst groß ist (siehe Abbildung a und b).[7] Sehr wichtig für die Funktion der Erythrozyten ist ihre starke Verformbarkeit, die es ihnen erlaubt, auch kleinste Kapillaren zu durchqueren. Durch den engen Kontakt zwischen Erythrozyten und dem Endothel der Gefäße ist der Gasaustausch in den Kapillaren besonders effektiv.
Sonderformen

Die Sichelzellenanämie ist gekennzeichnet durch sichelförmige Erythrozyten. Die Form geht zurück auf ein erblich abnormes Hämoglobin (Sichelzell-Hämoglobin, HbS), das bei Sauerstoffmangel zur Auskristallisation neigt und daher weniger Platz einnimmt, wodurch das Volumen der ganzen Zelle schrumpft. Heterozygot Betroffene sind jedoch vor den schweren Verlaufsformen der Malaria geschützt, da diese Zellen weniger durch Plasmodien angreifbar sind.
Unter speziellen Bedingungen können Erythrozyten Kugel-, Stechapfel- oder Becherform annehmen, meistens jedoch haben sie eine plattenähnliche Form. Sphärozyten sind kugelig-deformierte Erythrozyten, Echinozyten oder Stechapfelzellen (in der Zeichnung mit d markiert) weisen zudem zahlreiche (10–30) stumpfe Fortsätze auf und becherförmige Erythrozyten (c) werden als Stomatozyten bezeichnet. Diese Formen können durch Austrocknung oder andere Einflüsse entstehen. Sind Echinozyten jedoch trotz mehrfacher sorgfältiger Verarbeitung nachweisbar, kann dies in einer Pyruvatkinaseinsuffizienz, einer Niereninsuffizienz, einem Vitamin-E-Mangel (Hypovitaminose) oder einer Vergiftung begründet sein.
Ein Fragmentozyt oder Schistozyt ist ein geschädigter oder im Abbau befindlicher Erythrozyt bzw. ein Fragment eines Erythrozyten.
Bei sehr niedriger Fließgeschwindigkeit des Blutes können einzelne Erythrozyten aneinander haften und Ketten bilden, man spricht dann von einer Geldrollenbildung (in der Zeichnung mit b markiert) oder Agglomeration. Letztere kann zu Thrombosen führen. Treten solche in Herzkranzgefäßen auf, kann infolge des daraus resultierenden Sauerstoffmangels ein Herzinfarkt entstehen; im Gehirn ein Schlaganfall. Mittel dagegen sind Acetylsalicylsäure (ASS), Clopidogrel und Phenprocoumon (Marcumar).
Inhaltsstoffe
Erythrozyten bestehen zu 90 % der Trockenmasse aus dem Sauerstoff bindenden Protein Hämoglobin. Dies entspricht ca. 35 % der Masse eines Erythrozyten bzw. 120–160 g/l des Vollblutes bei Frauen und 140–180 g/l bei Männern. Der Häm-Anteil dieses Proteins verleiht den Erythrozyten und somit auch dem Blut die rote Farbe.

Kernlose Erythrozyten von Säugetieren
Die Erythrozyten von Säugetieren stoßen im Verlauf ihrer Reifung vom Erythroblasten ihren Zellkern und ihre Organellen aus, im Gegensatz zu anderen Wirbeltier-Klassen.[8][9] Da diese Erythrozyten keinen Zellkern besitzen, fehlt auch die DNA. Jedoch findet sich in der Zelle mRNA in kleinen Mengen. Durch den Abbau der Organellen wird zusätzlicher Platz für Hämoglobin geschaffen. Diese Erythrozyten besitzen auch keine Mitochondrien, Energie wird über die Glykolyse mit anschließender Milchsäuregärung bereitgestellt. Die Glucoseaufnahme der Erythrozyten wird dabei nicht über Insulin reguliert, da der entsprechende Rezeptor fehlt. Stattdessen erfolgt die Aufnahme von Glucose über andere Glucosetransporter (hier: GLUT-1).
Durch das Fehlen des Zellkerns können Säugetier-Erythrozyten sehr klein sein. Die nach bisherigen Erkenntnissen kleinsten Wirbeltier-Erythrozyten wurden schon im 19. Jahrhundert durch George Gulliver vom Java-Kantschil beschrieben, dem kleinsten Huftier der Welt.[10][5] Sie haben einen mittleren Durchmesser von 1,65 μm und eine Dicke von nur 0,83 μm.[11] Besonders vielfältig in der äußeren Form sind die Erythrozyten bei Hirschen. George Gulliver, der damals Assistenzarzt beim Royal Regiment of Horse Guards war, beschrieb 1840 die besonders hohe Formenvielfalt beim Weißwedelhirsch.[12] Wie bei der menschlichen Sichelzellkrankheit werden diese Formen durch unterschiedliche Varietäten des Hämoglobins hervorgerufen. Bei den Hirschen sind sie jedoch abhängig von Umgebungsbedingungen.[13]
Erythrozyten bei Vögeln und Reptilien
Obwohl die Erythrozyten von Vögeln einen Zellkern haben, teilen sie sich nicht.[14] In Versuchen mit markierten Zellen fand man gegenüber Säugetieren weiter verkürzte Lebensdauern. Alle markierten Erythrozyten waren bei Hausenten nach 42, bei Haushühnern nach 35 und bei Felsentauben nach 48 Tagen verschwunden.[14] Die verkürzte Lebensdauer könnte mit dem intensiveren Stoffwechsel bei Vögeln zusammenhängen.[15] Vogel-Erythrozyten sind meist oval scheibenförmig und durchweg die kleinsten mit Kern im Vergleich aller Wirbeltiere.[16] Die Abhängigkeit der Längen (10–18 μm), Breiten (5–7 μm), Dicken (2,4–3,8 μm) und Volumina von den Körpermassen der Vogelarten ist nur sehr gering.[16] Die kleinsten Volumina finden sich bei Sperlingsvögeln (63–110 μm3), die größten bei Pinguinen (229–255 μm3).[16] Erythrozyten von Laufvögeln liegen im Volumen lediglich bei 210 μm3.[16]
Die Abmessungen der Erythrozyten von Reptilien sind denen der Vögel in den Abmessungen sehr ähnlich.[10] Allerdings sind offenbar die Lebensdauern größer und liegen für Schildkröten bei 500 Tagen.[17] Für die Carolina-Dosenschildkröte werden Werte von 600 bis 800 Tagen angegeben.[18]
Erythrozyten bei Amphibien
Die größten Wirbeltier-Erythrozyten finden sich bei aquatischen Salamanderverwandten. Gulliver beschrieb schon 1875 ovale Erythrozyten des Dreizehen-Aalmolches mit Abmessungen von 70 μm × 41 μm.[10] Ähnlich große Zellen fand er auch beim Grottenolm, beim Großen Armmolch und beim Japanischen Riesensalamander.[10] Die Zellen der Aalmolche der Gattung Amphiuma gelten auch heute noch als die größten bekannten Erythrozyten bei Wirbeltieren.[5] Beim nördlichen Kammmolch sind die Abmessungen immerhin noch 30 μm × 20 μm, während bei Froschlurchen nur maximale Längen von 20 μm bis 24 μm gefunden wurden.[10] Als Lebensdauer werden für die Erythrozyten der Aga-Kröte Werte zwischen 2 und 4 Jahren angegeben.[18]
Erythrozyten bei Fischen
Echte Knochenfische haben Erythrozyten mit Abmessungen, die ähnlich denen der Vögel sind.[10] Für den Hecht und den Karpfen sind Abmessungen von 12 μm × 7 μm bekannt.[10] Bei Knorpelfischen sind die Erythrozyten größer und liegen mit den Abmessungen bei 25 μm × 16 μm.[10] Sehr große Abmessungen gibt es bei Lungenfischen, beim Westafrikanischen Lungenfisch zum Beispiel 45 μm × 27 μm.[10]
Funktion und Lebenszyklus
Die Hauptaufgabe der Erythrozyten ist der Sauerstofftransport im Blutgefäßsystem. Sie nehmen in den Lungenkapillaren oder Kiemen den Sauerstoff auf und transportieren ihn über den arteriellen Kreislauf bis in die arteriellen Kapillaren der Gewebe und Organe, von wo der Sauerstoff an die Zellen wieder abgegeben wird. Für die Bindung und den Transport des Sauerstoffs ist das Hämoglobin im Inneren der Erythrozyten verantwortlich. Hämoglobin transportiert teilweise auch das Kohlendioxid zurück aus den Geweben.
Der Prozess, bei dem die Erythrozyten entstehen, wird Erythropoese genannt. Im Embryo ist die Leber die Hauptproduktionsstätte der Erythrozyten. Später werden diese kontinuierlich im roten Knochenmark von größeren Knochen produziert. Sie entstehen dort aus teilungsfähigen Stammzellen, die zunächst kernhaltige Erythroblasten produzieren, aus denen dann zunächst unter Ausstoßung des Zellkerns die Retikulozyten und dann die eigentlichen Erythrozyten hervorgehen. Die im Knochenmark stattfindende Reifung der Erythrozyten wird von Makrophagen, einer Gruppe der Leukozyten (weiße Blutkörperchen), unterstützt. Hierbei ordnen sich die unreifen Erythrozyten in sogenannten „Inseln“ (englisch: Islands) um einen einzelnen Makrophagen an, der die Zellen versorgt und außerdem die ausgeschiedenen Zellorgane aufnimmt und verdaut. Dieser schon in den frühen 1940er Jahren beobachtete Vorgang benötigt auf noch nicht näher bekannte Weise das Retinoblastom-(Rb)-Protein. Die Entwicklung eines Erythrozyten dauert ca. 7 Tage. Ihre durchschnittliche Lebensdauer beträgt ca. 120 Tage bzw. 4 Monate. Die alternden Zellen verlieren nach und nach ihre Verformbarkeit und werden dann von Phagozyten in Leber, Milz und Knochenmark (RES = Retikuloendotheliales System) abgebaut und zu Galle verarbeitet.
In einem gesunden, erwachsenen Menschen befinden sich etwa 25 Billionen Erythrozyten, mit einer Gesamtoberfläche von 4000 m². Der Körper erneuert davon täglich ca. ein Prozent (200 Milliarden), was 2.000.000 in jeder Sekunde entspricht. Die Milz dient auch als Reservoir für Erythrozyten, wobei dieser Effekt beim Menschen limitiert ist. In anderen Säugetieren, wie beim Hund oder Pferd, enthält die Milz eine große Zahl von Erythrozyten, die bei Stress in den Blutkreislauf ausgeschieden werden und die Sauerstofftransportkapazität verbessern.
Die Produktion von Erythrozyten wird durch das Hormon Erythropoetin (EPO) stimuliert bzw. gesteuert, welches ständig von den Nieren neu gebildet wird, weil der Körper dieses Hormon nicht speichern kann. Bei vermindertem Sauerstoffgehalt des Blutes wird die Biosynthese von EPO in Gang gebracht. Dadurch passt sich der Körper zum Beispiel an die geringere Sauerstoffaufnahme bei Aufenthalten über 1500 m über NN an, etwa beim Höhentraining von Leistungssportlern. Synthetisches EPO kann auch als Dopingmittel eingesetzt werden.
Die Verlagerung des sauerstoffbindenden Proteins, in diesem Fall Hämoglobin, in Zellen hinein, statt dieses direkt in der Körperflüssigkeit zu lösen, war ein wichtiger Schritt in der Evolution der Wirbeltiere. Es ermöglicht dünnflüssigeres Blut sowie längere Transportstrecken des Sauerstoffes. Nur so ist auch die Versorgung eines größeren Organismus (bis hin zum Blauwal) mit Sauerstoff gewährleistet. Andere sauerstoffbindende Proteine aus anderen Tieren wie Hämocyanin, Hämerythrin oder Erythrocruorin können diese Eigenschaften nur annähernd über ihre Molekülgröße kompensieren.
Die kernhaltigen Erythrozyten der Fische, Amphibien und Vögel haben zudem Aufgaben in der Abwehr. Sie exprimieren etwa bei Anregung durch virale Antigene, die an ihre Toll-like-Rezeptoren binden, antivirale Gene (etwa für Interferone oder Interleukin-8). Zudem produzieren sie in Reaktion auf Bakterien oder Pilze entzündungsfördernde Zytokine, antimikrobielle Peptide oder Proteasomen. Die roten Blutzellen von Regenbogenforelle, atlantischem Lachs, Krallenfrosch und Haushuhn exprimieren den MHC-Klasse-I-Komplex und können Antigene präsentieren. Die Erythrozyten von Forellen und Hühnern phagozytieren beispielsweise Zellen des Pilzes Candida albicans und präsentieren aus ihnen gewonnene Antigene den Makrophagen. Fisch-Erythrozyten scheinen virale Antigene auch T-Zellen zu präsentieren, also nicht nur an der angeborenen, sondern auch an der erworbenen Abwehr beteiligt zu sein. Wird ein Erythrozyt von einem Pathogen infiziert, produziert das Hämoglobin reaktive Sauerstoffspezies und wirkt so antimikrobiell. Forellen- und Hühner-Erythrozyten bilden bei Infektionen zudem als Rosetten bezeichnete Zellaggregate, die die Ausschaltung der Pathogene durch Makrophagen fördern. Die Erythrozyten der Säugetiere haben mangels Kern, Mitochondrien und Golgi-Apparat deutlich weniger Immunsystem-Funktionen. Da ihre Oberfläche mit zahlreichen Rezeptoren besetzt ist, können sie jedoch Zytokine, mitochondrielle oder bakterielle DNA binden. Indem sie solche proinflammatorischen Signale sequestrieren, verringern sie die Aktivierung von Neutrophilen, was Immunreaktionen dämpft. Die Bindung von Pathogenen verringert das Risiko, dass diese andere Zellen befallen. Zudem können sie durch das Hämoglobin produzierte reaktive Sauerstoffspezies freisetzen.[19][20][21]
Krankheiten
- Bei einer Anämie oder Blutarmut ist in der Regel die Anzahl der Erythrozyten vermindert. Es gibt viele Ursachen für eine Anämie, wobei Eisenmangel der häufigste Grund in der westlichen Welt sein dürfte. Durch Eisenmangel wird die Häm-Synthese gehemmt. Als Folge sind die Erythrozyten hypochrom (vor allem im Zentrum schwächer rot gefärbt) und mikrozytär (kleiner als normal). Bei einer Gruppe von Stoffwechselkrankheiten, den Porphyrien, fallen Enzyme der Hämgruppen-Synthese teilweise aus und drosseln dadurch die Hämoglobinmenge in den Erythrozyten. Vorhandenes Eisen kann nicht vollständig in die Häm-Vorläufersubstanzen (Porphyrine) eingebaut werden, die im Gewebe akkumulieren und verschiedene Symptome verursachen (Lichtempfindlichkeit der Haut, starke Bauchschmerzen u. a.).
- Bei der Polyglobulie – z. B. der Polycythaemia vera, der Polycythaemia rubra hypertonica und der Polyglobulie des Neugeborenen – treten Erythrozyten vermehrt auf. Durch die erhöhte Anzahl der Thrombozyten bzw. Erythrozyten, wie im Falle der Polycythämie wird das Blut dickflüssiger. Es besteht die Gefahr einer Thrombose und in der Folge einer Embolie.
- Bei einer Hämolyse (verstärkter Abbau von Erythrozyten) tritt eine Gelbsucht auf, verursacht durch das Hämoglobin-Abbauprodukt Bilirubin. Außerdem können sich durch die Überladung mit Bilirubin Gallensteine in Form von Pigmentsteinen (Bilirubinsteinen) bilden.
- Mutationen in den Globinketten sind mit verschiedenen Hämoglobinopathien verbunden, wie der Sichelzellkrankheit und der Thalassämie. Bei der Sichelzellkrankheit handelt es sich um eine hauptsächlich in von Malaria betroffenen Gebieten vorkommende Krankheit. Bei ihr verformen sich die Erythrozyten im Deoxy-, das heißt sauerstoffarmen Zustand sichelförmig. In dieser Form können sie die kleinen Kapillaren nur mit Schwierigkeiten passieren und es kommt vermehrt zur Zerstörung der Erythrozyten, der sogenannten Hämolyse. Homozygote Träger dieser Erbanlagen haben eine deutlich verkürzte Lebenserwartung, die heterozygoten Träger sind jedoch in begrenztem Maße vor einer Malaria-Erkrankung geschützt, da der Erreger (Plasmodium falciparum) sich in derart deformierten Erythrozyten nicht vermehren kann.
- Die Kugelzellenanämie ist ein genetischer Defekt, bei dem kugelförmige Erythrozyten, sogenannte Sphärozyten, durch ein gestörtes Zytoskelett auftreten.
- Beim Favismus führt der genetisch bedingte Mangel an einem Enzym (Glucose-6-phosphat-Dehydrogenase) nach Einnahme bestimmter Medikamente (Acetylsalicylsäure) oder Nahrungsmittel (Saubohnen) zum Platzen der Erythrozyten.
Visualisierung
Aufgrund deren Größe benötigt man für die Betrachtung von Erythrozyten ein Mikroskop. Wegen der einfachen Anwendbarkeit wird standardmäßig optische Mikroskopie verwendet, geeignet ist dabei insbesondere die Dunkelfeldmikroskopie (Streulicht-Mikroskopie mit dunklem Hintergrund), bei der es nicht auf die (wenig kontrastreiche) (Auflicht-)Farbe, sondern auf die unterschiedliche Lichtstreuung der Blutkörperchen-Umrisse ankommt, mit der sich die Formen gut erkennen lassen.
Auch mittels photoakustischer Mikroskopie erhält man Bilder mit hohem Kontrast.[22][23]
Eine bessere örtliche Auflösung als mittels optischer Verfahren erhält man mit dem Rasterelektronenmikroskop. Allerdings benötigt man dafür eine spezielle Probenvorbereitung, beispielsweise das Beschichten der Erythrozyten mit einer leitfähigen Substanz.
Siehe auch
- Leukozyt (Weißes Blutkörperchen)
- Glykohämoglobin
- Fragmentozyt
- Erythrozytenverteilungsbreite
Ältere Literatur
- Ludwig Heilmeyer, Herbert Begemann: Blut und Blutkrankheiten. In: Ludwig Heilmeyer (Hrsg.): Lehrbuch der Inneren Medizin. Springer-Verlag, Berlin / Göttingen / Heidelberg 1955; 2. Auflage ebenda 1961, S. 376–449, hier S. 379–382 (Die Erythrocyten).
Weblinks
Einzelnachweise
- ↑ Wilhelm Gemoll: Griechisch-Deutsches Schul- und Handwörterbuch. München / Wien 1965.
- ↑ Bestandteile und Funktion des Blutes. Abschnitt: »Die Bestandteile des Blutes«. In: Onko-Internetportal Deutsche Krebsgesellschaft. Deutsche Krebsgesellschaft e. V., 21. März 2017, abgerufen am 29. Oktober 2022.
- ↑ Stichwort - Eisfische. Abgerufen am 14. Februar 2025.
- ↑ Swammerdam, Jan. Abgerufen am 14. Februar 2025.
- ↑ a b c d e Christopher D. Moyes, Patricia M. Schulte: Tierphysiologie. Pearson Studium, München 2008, ISBN 978-3-8273-7270-3, S. 426 (eingeschränkte Vorschau in der Google-Buchsuche – englisch: Principles of Animal Physiology. Übersetzt von Monika Niehaus, Sebastian Vogel).
- ↑ Robert F. Schmidt, Florian Lang, Manfred Heckmann: Physiologie des Menschen. mit Pathophysiologie. 31. Auflage. SpringerMedizin Verlag, Heidelberg 2010, ISBN 978-3-642-01650-9.
- ↑ Hermann Rein, Max Schneider: Einführung in die Physiologie des Menschen. 15. Auflage. Springer, Berlin 1964, S. 22 zu Stw. „Erythrozytenform“.
- ↑ Systematik der Wirbeltier-Klassen, Übersicht. (PDF) brunoschneider.ch
- ↑ Ehud Skutelsky, David Danon: An electron microscopic study of nuclear elimination from the late erythroblast. In: The Journal of Cell Biology, Band 33, Nr. 3, 1967, S. 625–635; doi:10.1083/jcb.33.3.625.
- ↑ a b c d e f g h i George Gulliver: Observations on the sizes and shapes of the red corpuscles of the blood of vertebrates, with drawings of them to a uniform scale, and extended and revised tables of measurements. In: Proceedings of the Zoological Society of London. 1875, S. 474–495. (Digitalisat)
- ↑ Katsuhiro Fukuta, Hiroshi Kudo, Syed Jalaludin: Unique pits on the erythrocytes of the lesser mouse-deer, Tragulus javanicus. In: Journal of Anatomy, 189, S. 211–213; PMC 1167845 (freier Volltext)
- ↑ George Gulliver: Observations on certain peculiarities of form in the blood corpuscles of the mammiferous animals. In: The London, Edinburgh, and Dublin Philosophical Magazine and Journal of Science Series. 3, 17 (111), 1840, S. 325–331. doi:10.1080/14786444008650186
- ↑ Ward D. Noyes, Hyram Kitchen, W. Yape Taylor: Red cell life span of white-tailed deer Odocoileus virginianus. In: Comparative Biochemistry and Physiology. Band 19, Nr. 2, 1966, S. 471–473 doi:10.1016/0010-406X(66)90155-1
- ↑ a b Colin G. Scanes (Hrsg.): Sturkie's Avian Physiology. 6. Auflage. Elsevier, Amsterdam 2015, ISBN 978-0-12-407160-5, S. 174.
- ↑ Roland Prinzinger, Andrea Misovic, Birgit Nagel: Aviäre Hämatologie: Das Vogelblut. Cuvillier, 2012, ISBN 978-3-95404-140-4, S. 44.
- ↑ a b c d Roland Prinzinger, Andrea Misovic: Vogelblut - eine allometrische Übersicht der Bestandteile. In: Journal für Ornithologie. Band 135, Nr. 2, 1994, S. 133–165.
- ↑ Thomas Vömel: Erythrozyten. In: Dieter Platt (Hrsgb.): Biologie des Alterns. De Gruyter, Berlin 1991, ISBN 3-11-012169-7, S. 85–90. doi:10.1515/9783110884791-008
- ↑ a b Paul D. Altland, Kirkland C. Brace: Red cell life span in the turtle and toad. In: American Journal of Physiology American Journal of Physiology. Band 203, 1962, S. 1188–1190. doi:10.1152/ajplegacy.1962.203.6.1188
- ↑ H. L. Anderson, I. E. Brodsky, N. S. Mangalmurti: The Evolving Erythrocyte: Red Blood Cells as Modulators of Innate Immunity. In: The Journal of Immunology, 2018, Band 201, Issue 5, S. 1343–1351; The American Association of Immunologists. doi:10.4049/jimmunol.1800565
- ↑ I. Nombela, M. del M. Ortega-Villaizan: Nucleated red blood cells: Immune cell mediators of the antiviral response. In: K. R. Spindler (Hrsg.): PLOS Pathogens, 2018, Band 14, Issue 4, S. e1006910. Public Library of Science (PLoS). doi:10.1371/journal.ppat.1006910
- ↑ M. Stosik, B. Tokarz-Deptuła, J. Deptuła, W. Deptuła: Immune Functions of Erythrocytes in Osteichthyes. In: Frontiers in Immunology, 2020, Band 11; doi:10.3389/fimmu.2020.01914
- ↑ E. M. Strohm et al.: Single Cell Photoacoustic Microscopy: A Review. In: IEEE Journal of Selected Topics in Quantum Electronics, 2016, 6801215; doi:10.1109/JSTQE.2015.2497323
- ↑ G. Langer et al.: Photoacoustic microscopy of single cells employing an intensity modulated diode laser. In: Proc. SPIE 10494, Photons Plus Ultrasound: Imaging and Sensing. 2018, 104942L (19. Februar 2018); doi:10.1117/12.2289978